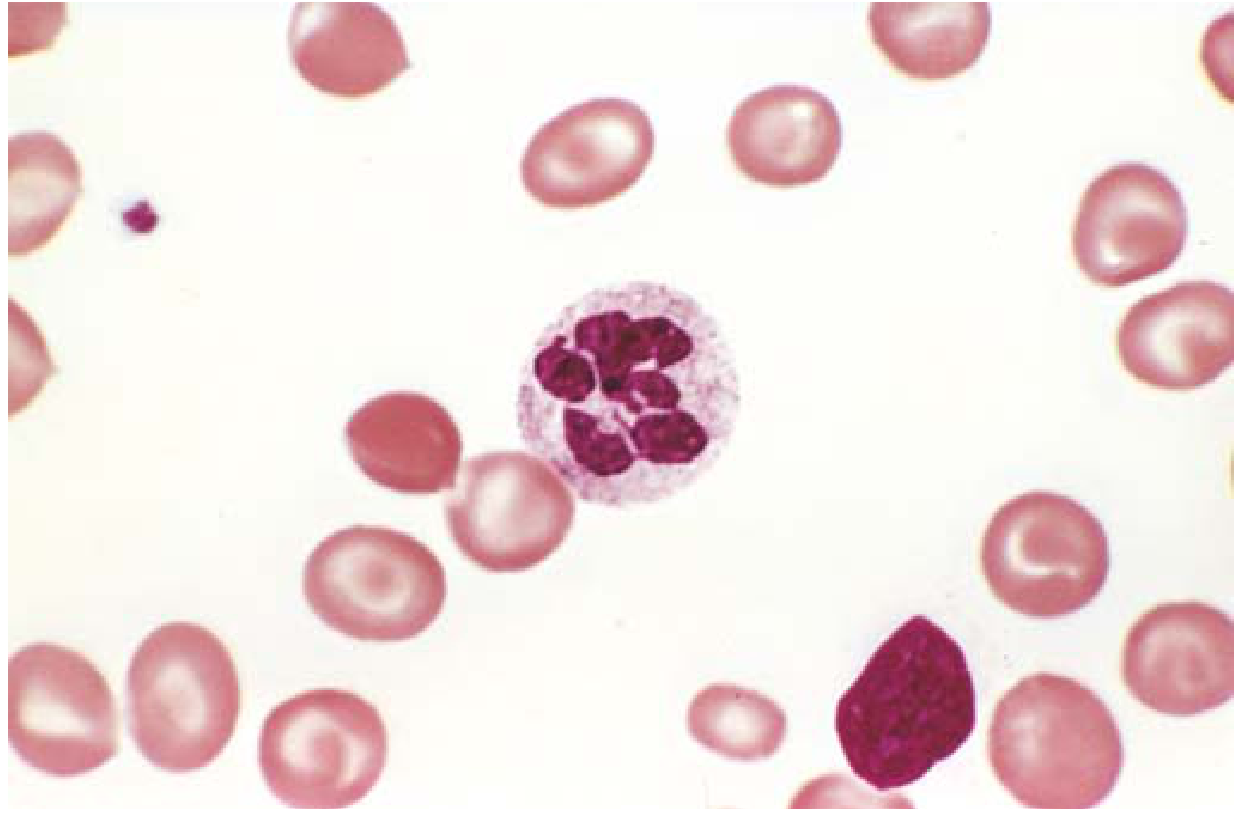

Role of Vitamin B12 and Folic acid in red blood cells production
Reading File
Finding Sources
Finding Sources
Reading File
Reading File
Reading File
Reading File
Finding Sources
Finding Sources
Reading File
Reading File
Reading File
Reading File
Reading File
Loading Image
Loading Image
Here is a comprehensive overview of the roles of Vitamin B12 and Folic Acid in red blood cell production, based on authoritative medical textbooks.
Vitamin B12 and Folic Acid in Red Blood Cell Production
Overview: Why Both Vitamins Are Essential
Red blood cell (RBC) production (erythropoiesis) is one of the most proliferative processes in the human body — roughly 2.5 to 3 million erythrocytes are produced every second. This extraordinary rate of cell division demands continuous DNA synthesis. Both vitamin B12 and folic acid are indispensable cofactors for this process.
"Because of the continuous proliferative activity of the erythroid tissue and the associated production of large amounts of hemoglobin, adequate nutritional supplies of folate, vitamin B12, and iron are essential for proper erythropoietic function." — Brenner and Rector's The Kidney
The Central Mechanism: DNA Synthesis
Both vitamins converge on a single critical step — the synthesis of thymidine (dTMP), one of the four building blocks of DNA.
"Vitamin B12 and folic acid are cofactors required for the synthesis of thymidine, one of the four bases found in DNA. A deficiency of these vitamins results in defective nuclear maturation due to deranged or inadequate DNA synthesis, with an attendant delay or block in cell division." — Robbins, Cotran & Kumar: Pathologic Basis of Disease
Role of Folic Acid (Folate)
- Folate is converted inside cells to tetrahydrofolate (THF), which acts as an acceptor and donor of one-carbon units.
- THF is essential for the synthesis of deoxythymidine monophosphate (dTMP) used in DNA replication.
- The conversion from dihydrofolate → tetrahydrofolate is catalyzed by dihydrofolate reductase (the target of the drug methotrexate).
- Folate deficiency also impairs synthesis of purines and disrupts amino acid metabolism.
"Tetrahydrofolate acts as an acceptor and donor of one-carbon units in several reactions that are required for the synthesis of deoxythymidine monophosphate (dTMP), which is used in DNA synthesis." — Robbins & Kumar Basic Pathology
Role of Vitamin B12 (Cobalamin)
- Vitamin B12 is required to recycle tetrahydrofolate — it regenerates the active THF form from methyltetrahydrofolate (methyl-THF).
- Without B12, folate becomes trapped as methyl-THF (the "folate trap"), making it unavailable for DNA synthesis even if dietary folate is adequate.
- B12 deficiency therefore impairs thymidine and purine synthesis by depleting methylenetetrahydrofolate and formyltetrahydrofolate respectively.
"In the case of vitamin B12 deficiency, thymidine and purine synthesis are impaired because of the unavailability of methylenetetrahydrofolate and formyltetrahydrofolate, respectively, and the trapping of folate as methyltetrahydrofolate." — Brenner and Rector's The Kidney
What Happens When These Vitamins Are Deficient: Megaloblastic Anemia
When either vitamin is deficient, DNA synthesis slows while RNA and protein synthesis continue normally, creating a characteristic nuclear-cytoplasmic asynchrony — large cells with immature nuclei called megaloblasts.
"Because the synthesis of RNA and cytoplasmic elements proceeds in parallel at a relatively normal rate and thus outpaces that of DNA, the hematopoietic precursors show nuclear-cytoplasmic asynchrony." — Robbins & Kumar Basic Pathology
Consequences:
| Effect | Explanation |
|---|---|
| Ineffective erythropoiesis | Erythroid progenitors trigger a DNA damage response → apoptosis |
| Fewer red cells | Progenitors mature after fewer cell divisions, reducing output |
| Pancytopenia | Granulocyte and platelet precursors are also affected |
| Macroovalocytes | Enlarged, oval red cells in peripheral blood (MCV often >110 fL) |
| Hypersegmented neutrophils | Neutrophils with ≥5 nuclear lobes |
| Elevated LDH & bilirubin | Markers of ineffective hematopoiesis and intramedullary cell death |
The most affected erythroid stage coincides with the end of EPO-dependent effects and the initiation of hemoglobin synthesis — the point at which a large pool of apoptosis-susceptible progenitors (CFU-Es and pro-erythroblasts) has been created.
Peripheral Blood Smear: Hallmark Finding
Megaloblastic anemia. A hypersegmented neutrophil (6-lobed nucleus) surrounded by macroovalocytic red cells — the classic peripheral blood finding in B12 or folate deficiency. — Robbins & Kumar Basic Pathology
Key Difference Between B12 and Folate Deficiency
| Feature | Folate Deficiency | Vitamin B12 Deficiency |
|---|---|---|
| Mechanism | Insufficient active THF for dTMP synthesis | Folate trap + direct impairment of THF recycling |
| Common cause | Poor diet, pregnancy, alcohol, malabsorption | Lack of intrinsic factor (pernicious anemia), ileal disease |
| Stores | Depleted in weeks to months | Depleted after 5–20 years (large hepatic reserves) |
| Neurologic damage | Absent | Present — demyelination of posterior and lateral spinal cord columns (subacute combined degeneration) |
| Treatment | Oral folic acid 1 mg/day | Parenteral or high-dose oral vitamin B12 |
"Folate administration does not prevent and may worsen neurologic symptoms that are specific to vitamin B12 deficiency." — Robbins & Kumar Basic Pathology
Vitamin B12 Absorption Pathway
Understanding absorption is critical because most B12 deficiency is due to malabsorption, not poor diet:

Vitamin B12 absorption. Dietary B12 → freed by pepsin → binds haptocorrin (saliva) → released by pancreatic proteases → binds intrinsic factor (IF, from gastric parietal cells) → IF-B12 complex absorbed in ileum via cubilin receptor → transported by transcobalamin II to liver and bone marrow. — Robbins & Kumar Basic Pathology
Common causes of B12 deficiency:
- Pernicious anemia — autoimmune destruction of gastric parietal cells → loss of intrinsic factor
- Gastrectomy, ileal resection, Crohn disease
- Strict veganism (no animal products)
Common causes of folate deficiency:
- Poor diet, alcohol use disorder
- Pregnancy (increased demand)
- Drugs: methotrexate, phenytoin, oral contraceptives
- Malabsorption (celiac disease)
Summary
Both B12 and folic acid are essential for the synthesis of DNA in rapidly dividing erythroid progenitors. Folate provides the one-carbon units needed to build thymidine; B12 keeps folate in its active form. Deficiency of either leads to the same hematologic picture — megaloblastic anemia — but only B12 deficiency additionally causes neurologic damage. This is why correct diagnosis matters: treating B12 deficiency with folate alone will correct the blood count but allow irreversible neurological injury to progress.
Sources: Robbins & Kumar Basic Pathology; Robbins, Cotran & Kumar Pathologic Basis of Disease; Brenner and Rector's The Kidney; Basic Medical Biochemistry — A Clinical Approach, 6e
This is a shared conversation. Sign in to Orris to start your own chat.